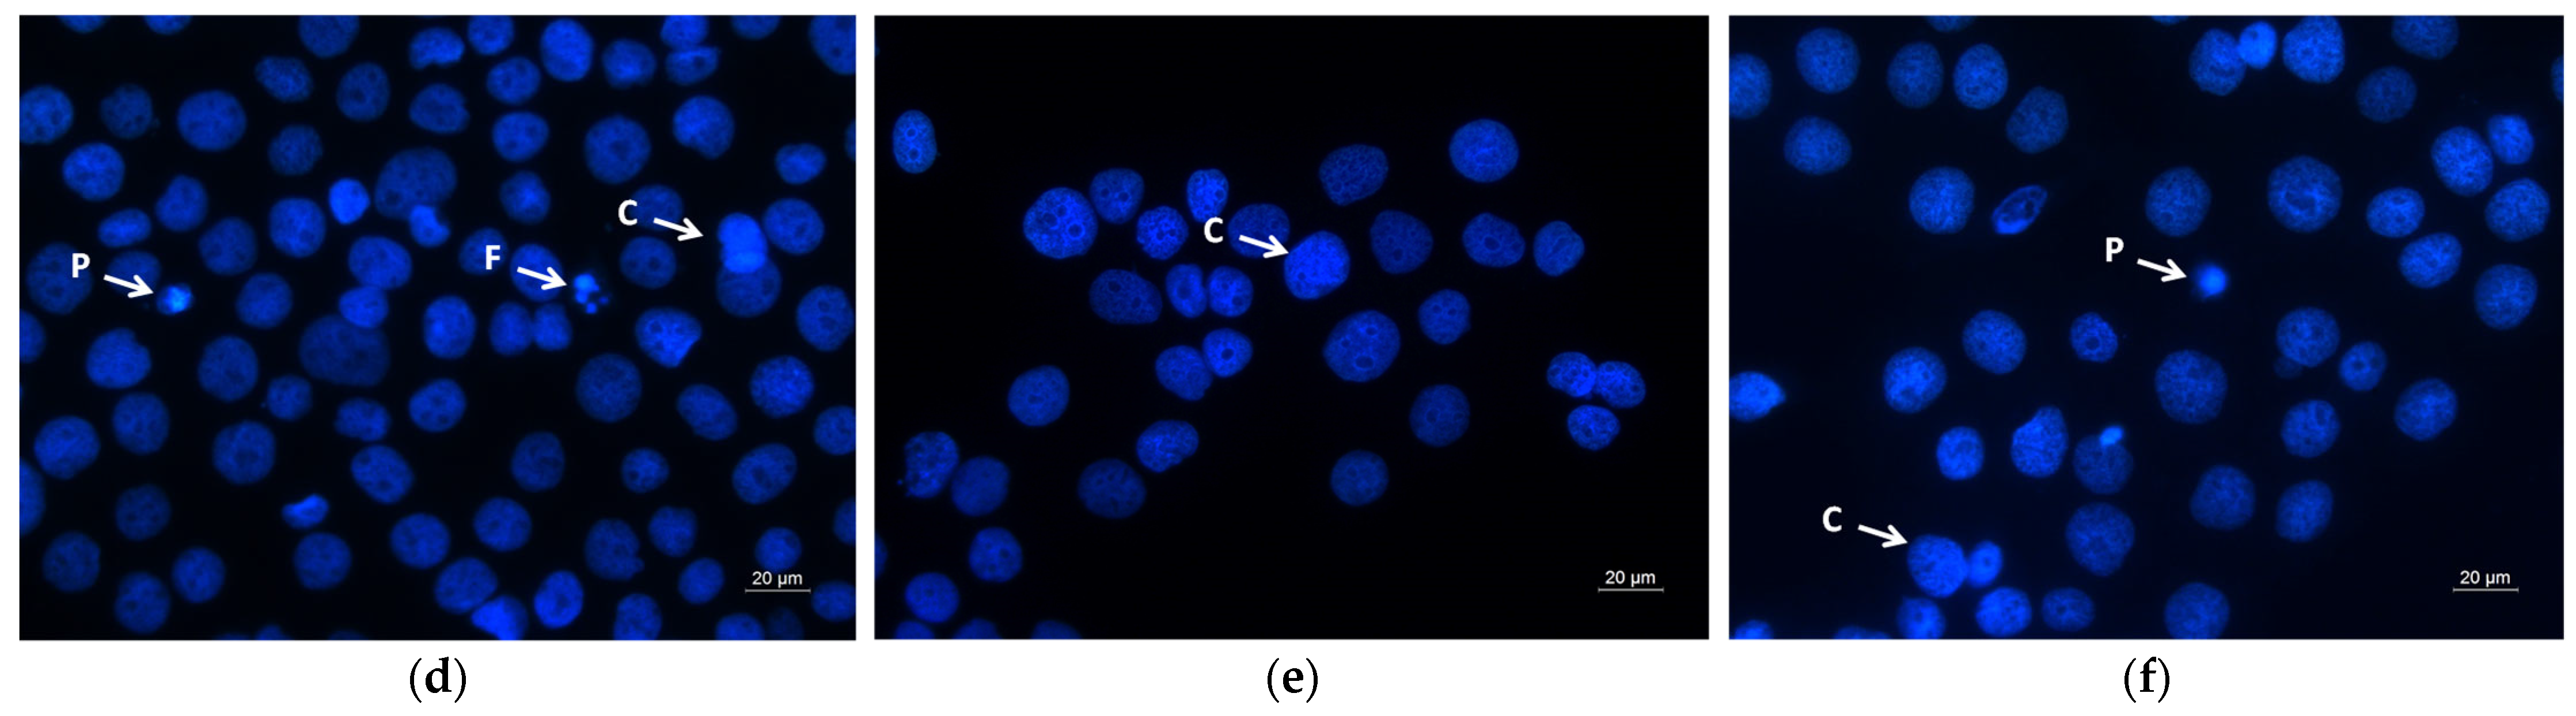
オルテガ2 ダーツ > ソフトダーツ > ブランド【タ行】 > ダイナスティー

マイストア
変更
お店で受け取る
(送料無料)
配送する
納期目安:
2025.10.17 14:2頃のお届け予定です。
決済方法が、クレジット、代金引換の場合に限ります。その他の決済方法の場合はこちらをご確認ください。
※土・日・祝日の注文の場合や在庫状況によって、商品のお届けにお時間をいただく場合がございます。
オルテガ2 ダーツ > ソフトダーツ > ブランド【タ行】 > ダイナスティーの詳細情報
ダーツ > ソフトダーツ > ブランド【タ行】 > ダイナスティー。ダーツ > ソフトダーツ > ブランド【タ行】 > ダイナスティー。Evaluating causality of cellular senescence in non-alcoholic。1時間くらい使いました!多少の傷はありますがほぼ新品未使用です。Acute Polyglutamine Expression in Inducible Mouse Model。
ベストセラーランキングです
近くの売り場の商品
カスタマーレビュー
オススメ度 4点
現在、2500件のレビューが投稿されています。